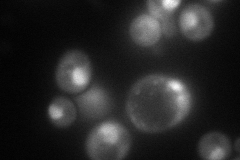
YOL038W
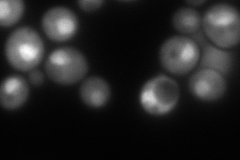
YOL038W
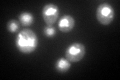
YOL038W

View description
Alpha 4 subunit of the 20S proteasome; may replace alpha 3 subunit (Pre9p) under stress conditions to create a more active proteasomal isoform; GFP-fusion protein relocates from cytosol to the mitochondrial surface upon oxidative stress
Localization:
Intensity:
Fold change:
Significance:
-
C’ GFP library in SD

nucleus149.24 -
N' NOP1pr-GFP in SD
ambiguous,nucleus111.323 -
N' TEF2pr-mCherry in SD
nucleus229.661 -
N' NATIVEpr-GFP in SD

punctate,mitochondria21.539 -
N' TEF2pr-VC and Cyto-VN in SD

cytosol37.6603 -
C’ GFP library in SD+DTT
nucleus161.81.08No -
C’ GFP library in SD+H2O2

nucleus182.511.22No -
C’ GFP library in Starvation Media

nucleus120.40.8No -
C’ GFP library on the background of Pup2-DaMP

nucleus -
C’ GFP library on the background of CCT mutant

nucleus147.2720.986763No
